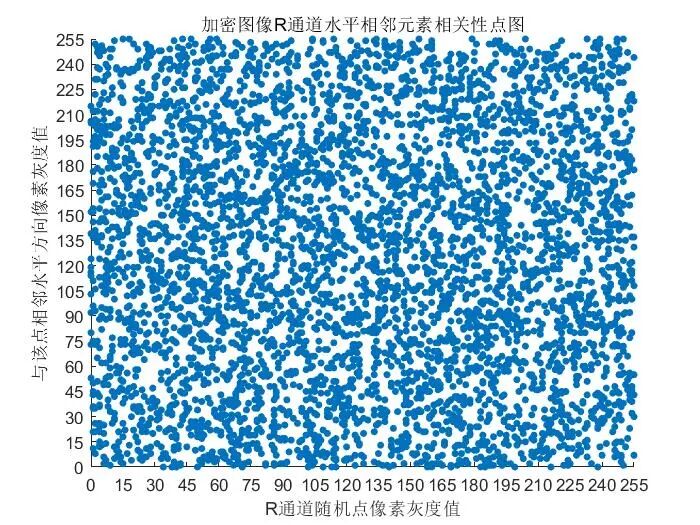
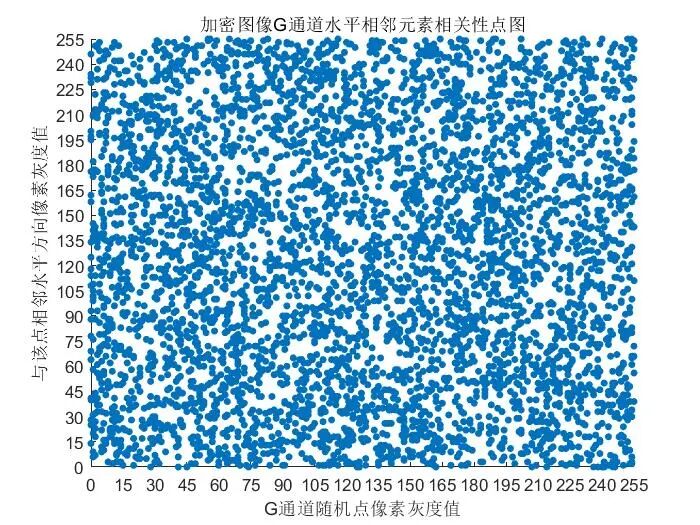
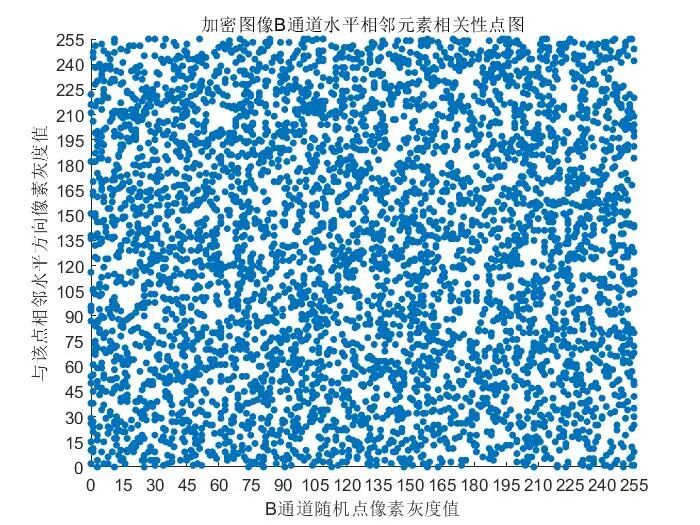

【图像加密】基于DNA结合arnold置乱变换实现彩色图像加密解密附Matlab代码
一、研究背景与问题提出(一)彩色图像加密的核心需求与安全挑战随着物联网、云计算与多媒体技术的快速发展,彩色图像作为信息传输与存储的核心载体,广泛应用于军事通信、医疗影像、金融数据等敏感领域。其加密保护的核心目标是在保证图像视觉质量无损恢复的前提下,抵御各类密码攻击(如穷举攻击、统计攻击、差分攻击),确保信息传输与存储的安全性。像素相关性高:相邻像素的灰度值差异小,易被攻击者通过统计分析破解;数据冗
✅作者简介:热爱科研的Matlab仿真开发者,擅长数据处理、建模仿真、程序设计、完整代码获取、论文复现及科研仿真。
🍎 往期回顾关注个人主页:Matlab科研工作室
👇 关注我领取海量matlab电子书和数学建模资料
🍊个人信条:格物致知,完整Matlab代码获取及仿真咨询内容私信。
🔥 内容介绍
一、研究背景与问题提出
(一)彩色图像加密的核心需求与安全挑战
随着物联网、云计算与多媒体技术的快速发展,彩色图像作为信息传输与存储的核心载体,广泛应用于军事通信、医疗影像、金融数据等敏感领域。其加密保护的核心目标是在保证图像视觉质量无损恢复的前提下,抵御各类密码攻击(如穷举攻击、统计攻击、差分攻击),确保信息传输与存储的安全性。然而,彩色图像的三维数据特性(R/G/B 三通道、像素点相关性强、数据量庞大)使其面临多重安全挑战:
- 像素相关性高:相邻像素的灰度值差异小,易被攻击者通过统计分析破解;
- 数据冗余度大:彩色图像的 R/G/B 通道存在一定相关性,传统加密算法难以充分混淆数据;
- 攻击手段多样:攻击者可通过选择明文攻击、差分攻击等方式,挖掘加密算法的漏洞;
- 实时性要求:图像数据量较大,加密解密过程需兼顾安全性与计算效率,避免耗时过长。
传统图像加密算法(如 AES、DES)虽适用于文本加密,但直接应用于彩色图像时存在局限性:加密粒度粗,难以破坏像素间的空间相关性;对彩色图像的三维结构适配性差,易导致加密效率低下或安全性不足。因此,亟需设计一种针对彩色图像特性的专用加密方案。
(二)DNA 编码与 Arnold 置乱的适配性与协同优势
DNA 计算作为一种基于生物 DNA 分子的新型信息处理技术,Arnold 置乱变换作为经典的混沌映射算法,二者在图像加密领域的协同优势显著:
- DNA 编码的核心优势:4 种碱基(A/T/C/G)可对应 2 位二进制数,实现数据的高密度存储与混淆;DNA 互补配对规则(A-T、C-G)提供了天然的加密 / 解密对称机制;碱基的生物化学反应特性可引入非线性变换,提升加密复杂度;
- Arnold 置乱的核心优势:基于混沌映射的像素位置置换,能快速破坏图像的空间相关性,使加密后的图像呈现均匀噪声分布;置乱次数与变换参数可作为密钥,增加密钥空间;
- 协同加密优势:Arnold 置乱负责像素位置的空间混淆,DNA 编码负责像素灰度值的数值混淆,二者结合实现 “位置 - 数值” 双重加密,大幅提升加密强度,有效抵御统计攻击与差分攻击。
基于此,本文提出一种基于 DNA 编码结合 Arnold 置乱变换的彩色图像加密解密方案,通过双模块协同工作,实现彩色图像的高安全性、高效率加密。
⛳️ 运行结果

📣 部分代码
function psnr = psnr(I, J)
% 计算消噪前后图像的峰值信噪比
psnr = 10 * log10( 255^2 / mse(I, J) );
🔗 参考文献
🎈 部分理论引用网络文献,若有侵权联系博主删除
🏆团队擅长辅导定制多种科研领域MATLAB仿真,助力科研梦:
🌟 各类智能优化算法改进及应用
生产调度、经济调度、装配线调度、充电优化、车间调度、发车优化、水库调度、三维装箱、物流选址、货位优化、公交排班优化、充电桩布局优化、车间布局优化、集装箱船配载优化、水泵组合优化、解医疗资源分配优化、设施布局优化、可视域基站和无人机选址优化、背包问题、 风电场布局、时隙分配优化、 最佳分布式发电单元分配、多阶段管道维修、 工厂-中心-需求点三级选址问题、 应急生活物质配送中心选址、 基站选址、 道路灯柱布置、 枢纽节点部署、 输电线路台风监测装置、 集装箱调度、 机组优化、 投资优化组合、云服务器组合优化、 天线线性阵列分布优化、CVRP问题、VRPPD问题、多中心VRP问题、多层网络的VRP问题、多中心多车型的VRP问题、 动态VRP问题、双层车辆路径规划(2E-VRP)、充电车辆路径规划(EVRP)、油电混合车辆路径规划、混合流水车间问题、 订单拆分调度问题、 公交车的调度排班优化问题、航班摆渡车辆调度问题、选址路径规划问题、港口调度、港口岸桥调度、停机位分配、机场航班调度、泄漏源定位、冷链、时间窗、多车场等、选址优化、港口岸桥调度优化、交通阻抗、重分配、停机位分配、机场航班调度、通信上传下载分配优化
🌟 机器学习和深度学习时序、回归、分类、聚类和降维
2.1 bp时序、回归预测和分类
2.2 ENS声神经网络时序、回归预测和分类
2.3 SVM/CNN-SVM/LSSVM/RVM支持向量机系列时序、回归预测和分类
2.4 CNN|TCN|GCN卷积神经网络系列时序、回归预测和分类
2.5 ELM/KELM/RELM/DELM极限学习机系列时序、回归预测和分类
2.6 GRU/Bi-GRU/CNN-GRU/CNN-BiGRU门控神经网络时序、回归预测和分类
2.7 ELMAN递归神经网络时序、回归\预测和分类
2.8 LSTM/BiLSTM/CNN-LSTM/CNN-BiLSTM/长短记忆神经网络系列时序、回归预测和分类
2.9 RBF径向基神经网络时序、回归预测和分类
2.10 DBN深度置信网络时序、回归预测和分类
2.11 FNN模糊神经网络时序、回归预测
2.12 RF随机森林时序、回归预测和分类
2.13 BLS宽度学习时序、回归预测和分类
2.14 PNN脉冲神经网络分类
2.15 模糊小波神经网络预测和分类
2.16 时序、回归预测和分类
2.17 时序、回归预测预测和分类
2.18 XGBOOST集成学习时序、回归预测预测和分类
2.19 Transform各类组合时序、回归预测预测和分类
方向涵盖风电预测、光伏预测、电池寿命预测、辐射源识别、交通流预测、负荷预测、股价预测、PM2.5浓度预测、电池健康状态预测、用电量预测、水体光学参数反演、NLOS信号识别、地铁停车精准预测、变压器故障诊断
🌟图像处理方面
图像识别、图像分割、图像检测、图像隐藏、图像配准、图像拼接、图像融合、图像增强、图像压缩感知
🌟 路径规划方面
旅行商问题(TSP)、车辆路径问题(VRP、MVRP、CVRP、VRPTW等)、无人机三维路径规划、无人机协同、无人机编队、机器人路径规划、栅格地图路径规划、多式联运运输问题、 充电车辆路径规划(EVRP)、 双层车辆路径规划(2E-VRP)、 油电混合车辆路径规划、 船舶航迹规划、 全路径规划规划、 仓储巡逻、公交车时间调度、水库调度优化、多式联运优化
🌟 无人机应用方面
无人机路径规划、无人机控制、无人机编队、无人机协同、无人机任务分配、无人机安全通信轨迹在线优化、车辆协同无人机路径规划、
🌟 通信方面
传感器部署优化、通信协议优化、路由优化、目标定位优化、Dv-Hop定位优化、Leach协议优化、WSN覆盖优化、组播优化、RSSI定位优化、水声通信、通信上传下载分配
🌟 信号处理方面
信号识别、信号加密、信号去噪、信号增强、雷达信号处理、信号水印嵌入提取、肌电信号、脑电信号、信号配时优化、心电信号、DOA估计、编码译码、变分模态分解、管道泄漏、滤波器、数字信号处理+传输+分析+去噪、数字信号调制、误码率、信号估计、DTMF、信号检测
🌟电力系统方面
微电网优化、无功优化、配电网重构、储能配置、有序充电、MPPT优化、家庭用电、电/冷/热负荷预测、电力设备故障诊断、电池管理系统(BMS)SOC/SOH估算(粒子滤波/卡尔曼滤波)、 多目标优化在电力系统调度中的应用、光伏MPPT控制算法改进(扰动观察法/电导增量法)、电动汽车充放电优化、微电网日前日内优化、储能优化、家庭用电优化、供应链优化\智能电网分布式能源经济优化调度,虚拟电厂,能源消纳,风光出力,控制策略,多目标优化,博弈能源调度,鲁棒优化
电力系统核心问题经济调度:机组组合、最优潮流、安全约束优化。新能源消纳:风光储协同规划、弃风弃光率量化、爬坡速率约束建模多能耦合系统:电-气-热联合调度、P2G与储能容量配置新型电力系统关键技术灵活性资源:虚拟电厂、需求响应、V2G车网互动、分布式储能优化稳定与控制:惯量支撑策略、低频振荡抑制、黑启动预案设计低碳转型:碳捕集电厂建模、绿氢制备经济性分析、LCOE度电成本核算风光出力预测:LSTM/Transformer时序预测、预测误差场景生成(GAN/蒙特卡洛)不确定性优化:鲁棒优化、随机规划、机会约束建模能源流分析、PSASP复杂电网建模,经济调度,算法优化改进,模型优化,潮流分析,鲁棒优化,创新点,文献复现微电网配电网规划,运行调度,综合能源,混合储能容量配置,平抑风电波动,多目标优化,静态交通流量分配,阶梯碳交易,分段线性化,光伏混合储能VSG并网运行,构网型变流器, 虚拟同步机等包括混合储能HESS:蓄电池+超级电容器,电压补偿,削峰填谷,一次调频,功率指令跟随,光伏储能参与一次调频,功率平抑,直流母线电压控制;MPPT最大功率跟踪控制,构网型储能,光伏,微电网调度优化,新能源,虚拟同同步机,VSG并网,小信号模型
🌟 元胞自动机方面
交通流 人群疏散 病毒扩散 晶体生长 金属腐蚀
🌟 雷达方面
卡尔曼滤波跟踪、航迹关联、航迹融合、SOC估计、阵列优化、NLOS识别
🌟 车间调度
零等待流水车间调度问题NWFSP 、 置换流水车间调度问题PFSP、 混合流水车间调度问题HFSP 、零空闲流水车间调度问题NIFSP、分布式置换流水车间调度问题 DPFSP、阻塞流水车间调度问题BFSP
👇
5 往期回顾扫扫下方二维码

DAMO开发者矩阵,由阿里巴巴达摩院和中国互联网协会联合发起,致力于探讨最前沿的技术趋势与应用成果,搭建高质量的交流与分享平台,推动技术创新与产业应用链接,围绕“人工智能与新型计算”构建开放共享的开发者生态。
更多推荐
 已为社区贡献275条内容
已为社区贡献275条内容







所有评论(0)